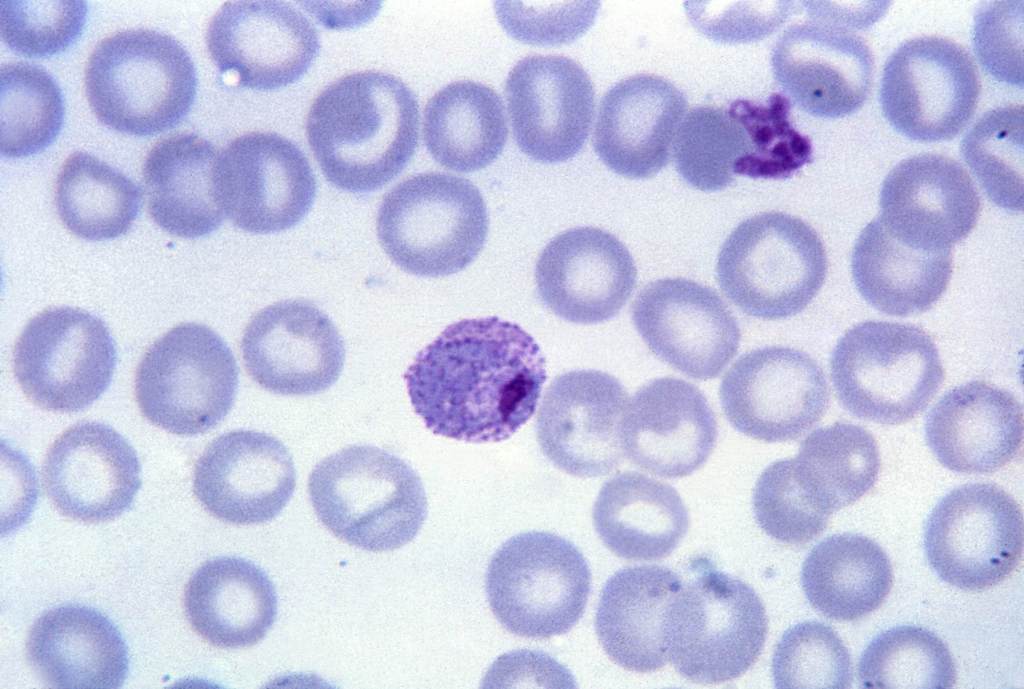

Research sponsored by Just Tea LLC – ‘Revive your health with handcrafted teas brewed since 1994.’
If you prefer to listen to a video of this blog:
Warning: if you are uncomfortable with graphic photos of parasites, please be aware this post has example photos of each type within its content. Scroll to the bottom if you’re interested solely on Essiac and it’s role on parasites.
What are Parasites?
There are three main types of parasites humans are infected with; protozoa, helminths (parasitic worms), and ectoparasites.
1. Protozoa
Description: Protozoa are microscopic, one-celled organisms.
Reproduction: Can multiply within the human host.
Transmission: Contaminated food or water, or person-to person contact.
Examples:
Entamoeba histolytica – causes dysentery.

Plasmodium – causes malaria, transmitted by mosquitos.
2. Helminths
Description: Helminths are large, multicellular organisms, commons known as worms.
Reproduction: Cannot multiply in humans, adult forms are visible to the naked eye.
Transmission: Ingestion of eggs or larvae in contaminated food or water.
Examples:
Roundworms (Ascaris lumbricoides) – can grow up to 35cm and live in the intestines.

Tapeworms (Taenia) – Long, flat worms that absorb nutrients from the host’s intestines.

Pinworms (Enterobius vermicularis) – small, thin white parasitic worms.

Flukes (Clonorchis sinensis) – Can infect the liver and bile ducts.

3. Ectoparasites
Description: Organisms that live on the outside of the host.
Reproduction: Generally do not multiply within the host.
Transmission: Often spread through direct contact or bites.
Examples:
Lice: infest hair and skin, causing itching.

Fleas: Blood-sucking insects that can transmit diseases.

Mites: tiny arachnids which cause skin issues – most notably scabies.

Parasitic Infection Risk Factors
Certain Risk factors increase the likelihood of contracting a parasitic infection.
Infected Water
Infected water is the most common factor of parasitic infections, particularly in regions with inadequate or non-existent water treatment systems.
International Travel
International travel, especially if the destination has poor sanitation and hygiene practices.
Mishandled Food
Another significant risk factor is food that has been mishandled, stored incorrectly, or undercooked. Produce that hasn’t been thoroughly cleaned can also carry parasites from contaminated soil, water or improper storage.
Direct Contact
Direct contact with infected individuals or animals can transmit certain parasites such as pinworms or lice.
Symptoms of Parasites
Symptoms depend on the type of parasite and can vary widely, ranging from mild GI discomfort to nutritional deficiencies, chronic illness, and even severe organ damage.
Common symptoms include:
Abdominal Pain
Gas and bloatin
Diarrhea
Constipation
Fatigue
Skin Rash
Genital Itching
Changes in appetite
Food cravings
Blood sugar imbalances
Unexplained weight loss
Malaise – a vague feeling of bodily discomfort, as at the beginning of an illness.
In some cases, parasites can go dormant and reactivate when the immune system is weakened. Also, infections can often be asymptomatic (no symptoms), which is why regular check-ups are critical, especially after traveling to high-risk areas.
Detecting Parasites
Protozoa: an ova and parasite test (O&P) looks for intestinal parasites and their eggs in a stool sample under a microscope. PCR tests are also used to detect protozoa in stool samples, offering faster and more sensitive results.
Helminth: the most common test is a stool examination, an O&P test. Additional methods like endoscopy or blood tests may be used if initial tests are inconclusive.
Ectoparasites: skin scrapings, adhesive tape tests and visual inspections are the most common methods for detecting ectoparasites.
Parasite Treatments
Antiparasitic Drugs
Common treatments include drugs like metronidazole, tinidazole, and nitazoxanide.
Herbal Remedies
There are several method to help cleanse parasites from the body, some more effective than others. Cleanses typically involve using natural remedies, supplements, and dietary and lifestyle changes to remove parasites from the body. Certain herbs and lifestyle practices create an unfavorable environment for parasites which support the body’s natural immune defenses.
Severe parasitic infections may require additional medical intervention.
Remedies such as wormwood, black walnut hulls, clove, garlic and oregano oil have a long-standing history in traditional medicine for combating parasitic infections.
Wormwood (Artemisia annua L.) – is rich in artemisinin which is shown to be effective against a wide range of parasites. Artemisinin derivatives possess potent antiparasitic activity which damages the cellular structure of parasites.
Black Walnut Hulls – rich in juglone, a natural compound toxic to parasites, including tapeworms and flukes. Juglone also offers other significant health benefits, including antidiabetic, antimicrobial, anti-inflammatory, anticancer, antioxidant, and immunoregulatory properties.
Essential Oils – derived from herbs such as clove, thyme, oregano, and basil are recognized for their potential to eliminate parasite eggs and larvae. Research shows that when used at concentrations as low at 0.1 percent, 96% of nematode larvae were killed.
Enhance Stomach Acidity
Stomach acid should have a pH of around 1.5 to 3.5 but influences such as stress, aging and diets high in processed food can lead to a more alkaline environment, increasing the risk of parasites.
Apple cider vinegar, taken before meals, can stimulate stomach acid secretion and aid in digestion, which may help reduce the risk of parasitic infections.
Probiotics
Probiotics are live beneficial microorganisms that provide various health benefits and may help the body defend against certain parasitic infections. Research has shown that probiotics enhance immune response and create natural compounds, such as lactic acid and reuterin, which are potent antimicrobial agents. Incorporating probiotic-rich foods, such as yogurt, kefir and sauerkraut, may provide support in combating parasitic infections as well as overall digestive health.
Keto & Intermittent Fasting
Many parasites thrive on glucose, and following a low-carb diet can help inhibit parasitic growth. Healthy keto also supports strong immune functions by reducing the inflammatory effects of high sugar intake.
Intermittent fasting triggers a process called autophagy, a natural detoxification process in which the body recycles old and damaged cell material. This allows the enhancement of your immune system and provides improves overall cellular function.
Treatment Risks
It is always advised to approach parasitic treatments with caution. Some can do more harm than good, causing side effects such as allergic reactions or GI upset.
Some compounds such as juglone and artemisinin, while effective against parasites, can also be toxic to humans if not properly used.
Overuse or misuse of treatments can contribute to resistant strains of parasites, making infections more challenging to treat.
It is advised to consult with a healthcare professional to ensure your chosen method is safe and appropriate for your specific health needs.
When to see a Doctor
Certain aggressive parasitic infections can lead to severe symptoms such as dehydration, malnutrition, or organ damage. It’s critical to consult a healthcare professional if you suspect you have a parasitic infection or developed unexplained health issues. Seek medical treatment if you experience the following symptoms:
Fever, Headaches, severe diarrhea, bloody stool, vomiting, abdominal pain, confusion, vision problems, seizures, abdominal cramping, extreme thirst, elevated heart rate, weakness.
Early intervention is key to preventing complications and ensuring effective treatment.
Can Essiac help with Parasites?
The short answer is yes. Each of the 4 herbs plays a role in making a hostile environment for parasites as well as the mechanisms which expel them.
Burdock Root
Burdock root is not typically classified as a primary herb for killing parasites directly, but is widely used in herbal formulas to support the body during parasite cleanses by acting as a blood purifier and helping to eliminate toxins released when parasites die.
Detoxification Support: Burdock root helps remove accumulated waste and toxins from the skin, kidneys, mucous, and serous membranes, which is crucial for managing the “die-off” reaction when parasites are being eliminated by other herbs.
It is frequently combined with potent anti-parasitic herbs like wormwood, black walnut hull, and clove in commercial blends designed to rid the body of intestinal worms and support immune defense.
Blood and Organ Cleansing: While it does not directly expel parasites, burdock is noted for its ability to cleanse the blood and strengthen the liver, creating an environment less hospitable to parasitic organisms and aiding the body in flushing out harmful organisms.
Turkey Rhubarb
Turkey Rhubarb has strong laxative and purgative properties that help expel intestinal worms by stimulating bowel movements.
The plant’s anthraquinones act as a cathartic to mechanically clear the gut, which is believed to help expel worms, though this effect is mechanical rather than antimicrobial against the parasites themselves.
Traditional Chinese Medicine (TCM) systems have historically recommended rhubarb for digestive complaints associated with parasitic infections, such as bloating and irregular digestion but not to rid the body of parasites directly.
Slippery Elm
Slippery elm bark is used in parasite cleanses primarily to soothe and protect the digestive tract rather than directly killing parasites. Its high mucilage content creates a slippery environment in the gut that makes it difficult for parasites to attach to intestinal walls, potentially aiding in their expulsion.
While slippery elm itself is not a direct antiparasitic agent like wormwood or black walnut, it is frequently combined with other herbs (such as wormwood, black walnut, and clove) to support the body during a cleanse. It helps alleviate symptoms like cramps, diarrhea, and nausea associated with parasitic infections by reducing inflammation and coating the digestive lining.
It is often taken as a supplement, powder, or tea, sometimes in formulations that also include direct antiparasitic herbs like Pau d’Arco or Ginger root.
Sheep Sorrel
Sheep sorrel is traditionally used as a vermifuge (dewormer) to eliminate intestinal parasites and worms, as the plant allegedly contains compounds considered toxic to intestinal parasites.
The plant’s effectiveness is attributed to its oxalic acid content, which gives it anti-parasitic properties alongside its anti-inflammatory and anti-microbial effects.
Sheep sorrel is often included in herbal formulations, such as Para-Yeast for pets, to help control yeast overgrowth and act as a natural wormer.
References
https://www.cdc.gov/parasites/about/index.html
Parasites: Types, Symptoms, Treatment & Prevention
https://my.clevelandclinic.org/health/diseases/24911-parasites
https://www.manhattangastroenterology.com/10-signs-you-may-have-a-parasite/
https://www.nm.org/healthbeat/healthy-tips/what-to-do-if-you-think-you-have-a-parasite
https://medlineplus.gov/lab-tests/ova-and-parasite-test/
https://www.cdc.gov/parasites/testing-diagnosis/index.html
How to Test for Gastrointestinal Parasites in Humans
https://news.mayocliniclabs.com/infectious-disease/gi-parasitic-disease/ova-and-parasite-testing/
https://www.drberg.com/blog/the-best-home-remedies-for-parasites
https://www.sciencedirect.com/science/article/abs/pii/S1043661817310423
https://www.sciencedirect.com/science/article/abs/pii/S1567576922009006
https://www.imrpress.com/journal/FBE/15/4/10.31083/j.fbe1504025
https://www.scielo.br/j/bjps/a/Br3dCGL7d8Ws4Sqdp6hJz8B/?format=html&lang=en
https://www.frontiersin.org/journals/immunology/articles/10.3389/fimmu.2020.623989/full